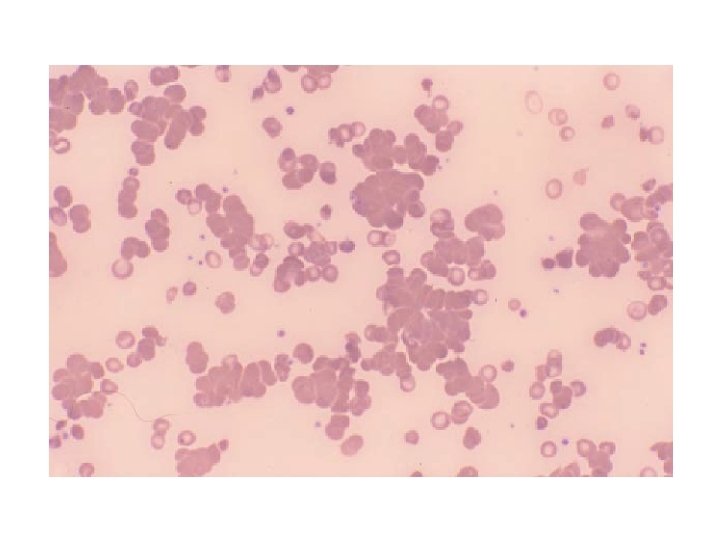

Acquired Hemolytic Anemias Prof Dr S Sami Kart

- Slides: 49
Acquired Hemolytic Anemias Prof. Dr. S. Sami Kartı
General features (I) • Acquired hemolytic anemias are divided into two main types: immune and non-immune • The abnormalities are extrinsic to the erythrocyte except paroxysmal nocturnal hemoglobinuria (PNH), which is an acquired genetic lesion • The laboratory tests show an increased reticulocyte count (or reticulocyte production index), increased bilirubin and lactic dehydrogenase, and decreased haptoglobin.
IMMUNE HEMOLYTIC ANEMIAS
General features (II) • • • Immune hemolytic anemias may be primary (idiopathic) or secondary may be acute or chronic Immune-mediated hemolysis may occur due to drugs or medications Antibodies are mainly of Ig. G or Ig. M types Antibody may also bind (and activate) complement
Cold-Reactive Immune Hemolytic Anemia Do not confuse cold agglutinins with cryoglobulins. Cold agglutinins are antibodies that cause agglutination of erythrocytes at cold temperatures. Cryoglobulins are antibodies that aggregate at cold temperatures (no erythrocytes involved)
Primary (Idiopathic) Cold Agglutinin Disease • Usually occurs in older individuals (peak age about 70 years) • More common in women than men • The course is usually chronic, lasting for months or years • The anemia is usually modest • Main symptoms are related to agglutination of erythrocytes on exposure to cold rather than the anemia • Some patients have a lymphoproliferative disorder such as chronic lymphocytic leukemia (CLL), Waldenström’s macroglobulinemia, or non-Hodgkin’s lymphoma • Other patients do not have an obvious lymphoproliferative disorder at the onset of the cold agglutinin disease but may develop one later
Secondary Cold Agglutinin Disease • Most often related to infections, primarily Mycoplasma pneumoniae or Epstein-Barr virus (EBV) (infectious mononucleosis) • It can occasionally occur with other viral infections (adenovirus, cytomegalovirus, rubella, mumps, HIV), bacterial infections (Legionella, Escherichia coli, Listeria), malaria, syphilis, and others • The patients are usually young and otherwise healthy • The onset is abrupt, usually as the infection is resolving • The antibodies are polyclonal and usually directed against the I/i blood group.
Diagnosis of Cold Agglutinin Disease • On the routine CBC; RBC count decreases, mean corpuscular volume (MCV) increases • On the blood smear, large round clusters of RBCs are seen, spherocytes may be present • Direct antiglobulin test (DAT or Coombs’ test) detects the presence of complement components (but not Ig. G) on the surface of the patient’s RBCs • The thermal amplitude is measured by determining the titer of the antibody at various temperatures, ranging from 4ºC to 37ºC. • Clinical severity depends more on thermal amplitude than titer; antibodies that react at higher temperatures are associated with more severe clinical disease
Direct antiglobulin test (DAT) (direct Coombs’ test) • Shows antibody or complement on the patient’s RBCs. • The direct antiglobulin test uses the patient’s cells and adds a reagent serum. • It is performed by adding antibodies directed against either human Ig. G, complement components, or both (the antiglobulin or Coombs’ reagent) to the patient’s RBCs and seeing if the cells agglutinate.
Antibody screen (indirect antiglobulin test) (indirect Coombs’ test) • Detects unexpected anti-erythrocyte antibodies in the patient’s serum • The patient’s serum is added to panels of reagent red cells • After the cells and serum have incubated, the cells are washed an antiglobulin reagent is added • If there are unexpected antibodies in the patient’s serum, the reagent cells will agglutinate; otherwise, the reagent cells do not agglutinate
Treatment of Cold Agglutinin Disease (I) Primary Cold Agglutinin Disease • Patients should avoid cold temperatures and take precautions to keep the extremities warm • In mild cases, this may be sufficient. The anemia is usually mild and does not require transfusions or specific therapy. • In patients who require furtherapy, cyclophosphamide (Endoxan) or chlorambucil given orally may be helpful.
Treatment of Cold Agglutinin Disease (II) Secondary Cold Agglutinin Disease • Infection-related cold agglutinin disease is usually transient, lasting only a few weeks. Supportive therapy is usually all that is needed. • Blood transfusions should be avoided, if possible, but should be given if necessary. • It is often difficult for the blood bank to obtain units that are completely cross-match compatible.
Paroxysmal Cold Hemoglobinuria (I) • Paroxysmal cold hemoglobinuria (PCH) is an unusual and now rare syndrome characterized by intravascular hemolysis and consequent hemoglobinuria following exposure to cold • It is caused by a peculiar biphasic Ig. G antibody that reacts and fixes complement at cold temperatures • After rewarming, the complement cascade goes to completion with formation of the membrane attack complex and intravascular hemolysis due to complement lysis • The antibody has been designated the Donath. Landsteiner antibody and is usually directed against the P blood group antigen
Paroxysmal Cold Hemoglobinuria (II) Paroxysmal cold hemoglobinuria is seen in three clinical forms • An acute form that follows an infection, like viral infections (measles, measles vaccine, mumps, adenovirus, EBV, cytomegalovirus) or Mycoplasma pneumoniae • A chronic form associated with tertiary or congenital syphilis • A chronic idiopathic form Paroxysmal cold hemoglobinuria is a relatively common cause of acute hemolytic anemia in children
Warm-Reactive Immune Hemolytic Anemia • Warm-reactive immune hemolytic anemia is more common than the cold-reactive variant (at least 70% of immune hemolytic anemias) • It can be primary (idiopathic), secondary to a wide variety of different conditions, or drugrelated • Most cases (about 80%) are due to some underlying condition, although this may not be apparent at the onset of hemolysis • Hemolytic anemia may be the presenting feature of SLE or other autoimmune disorder • The idiopathic variety is more common in women and the older population
Causes of Warm-Reactive Immune Hemolytic Anemia
Pathophysiology • The antibody is usually a “panagglutinin, ” meaning that the patient’s antibody will react with virtually all RBCs • The antibody is almost always an Ig. G. Occasionally, an Ig. A or Ig. M antibody will be seen • The antibody often fixes complement to the red cell but usually does not proceed through the complete membrane attack complex • Occasionally, there is sufficient complement activation on the RBC, resulting in formation of the membrane attack complex and intravascular hemolysis • Red cell destruction is primarily by phagocytosis by splenic macrophages
Clinical Manifestations • The severity of illness varies from an asymptomatic increase in red cell turnover completely compensated by increased marrow production to a fulminant illness with prostration, shock, and acute renal failure • The majority of patients experience an insidious onset of fatigue, weakness, and shortness of breath on exertion • Angina may be a presenting feature in older patients with coronary artery disease • Jaundice may be present • Mild splenomegaly and hepatomegaly may be present on examination, as well as mild lymphadenopathy; however, marked hepatosplenomegaly or lymphadenopathy suggests an underlying lymphoproliferative disorder • The course in adults tends to be chronic, lasting months to years, with periodic exacerbations
Diagnosis • The hemoglobin level is variable, from severely decreased to nearly normal • The MCV is typically slightly increased due to reticulocytosis • The peripheral blood smear shows polychromasia and microspherocytes; in severe cases, nucleated RBCs may be present • The reticulocyte count and reticulocyte production index are increased • The bilirubin and lactic dehydrogenase are variably elevated, and the haptoglobin is decreased • The most important diagnostic test is the direct antiglobulin test (DAT), which is positive in >95% of cases • In most cases, the DAT is positive for Ig. G, with or without complement; a smaller number are positive for complement alone (<15%) • The antibody screen (indirect antiglobulin test) is positive in about 80% of cases
Treatment (I) • Any possible primary cause (such as an underlying autoimmune disease or lymphoproliferative disorder) should be treated appropriately • It is preferable to avoid red cell transfusions, but they should be given if needed • The blood bank will usually not be able to find totally compatible units for transfusion but may be able to select least incompatible units • In general, transfusion does not cause a significant increase in hemolysis, and the transfused red cells survive about as long as the patient’s own RBCs
Treatment (II) • The mainstay of initial therapy is corticosteroids, such as prednisone (1– 2 mg/kg/day in divided doses) • Most patients show a response within 3 weeks • Corticosteroids block the macrophage Fc receptors and thus prevent RBC phagocytosis • They can also decrease antibody production by the spleen, but this takes several weeks • Prednisone is usually continued at the original dose until the hemoglobin is 10 g/d. L; the dose is then slowly tapered down by 5 to 10 mg/week to approximately 10 mg/day
Treatment (III) • If the hemoglobin remains stable, then the dose is slowly tapered again over 3 to 4 months • About 80% of patients initially respond; however, about two-thirds of responders relapse as the drug is tapered. Some patients can be maintained on no corticosteroids or on a low dose • Patients requiring more than 10 to 20 mg of prednisone per day, or patients having intolerable side effects on prednisone, should be considered for splenectomy
Treatment (IV) • Splenectomy is the mainstay of therapy for patients who fail to respond to corticosteroids or who require excessive doses to maintain remission. • Splenectomy eliminates the primary site of red cell destruction and also removes an important site of antibody production. • Approximately 50 to 60% of patients have a good initial response to splenectomy. • Patients should be vaccinated against pneumococcus, h. influenza B and meningococcus prior to surgery. • Otherapies that are sometimes used include immunosuppressive drugs like cyclophosphamide or azathioprine, intravenous immunoglobulin, plasmapheresis, vincristine or vinblastine, and danazol. • Intravenous immunoglobulin and plasmapheresis may be helpful, but the effects are transient.
Drug-Related Immune Hemolytic Anemia • Drugs and medications are common causes of immune hemolytic anemia (~10– 20% of cases) • The hemolysis is almost always of the warmreactive type • A variety of medications develop a positive DAT; however, actual hemolysis is rare • Three mechanisms of drug-related immune hemolytic anemia have been described
Drug adsorption (penicillin) type • The drug binds tightly to the RBC surface antigen, and an antidrug antibody reacts with the drug the red cell antigen complex • The DAT is positive for Ig. G, with or without complement. • Hemolysis is usually extravascular in the spleen; rarely, there may be intravascular hemolysis if the antibody fixes complement • The hemolysis is usually subacute, not severe • It occurs only with high doses of penicillin (>10 million units/day) in a small minority of patients • a higher proportion of patients develop a positive DAT, without hemolysis • This type of reaction may also be seen with cephalosporin antibiotics, tetracycline, and tolbutamide
Neoantigen (immune complex) type • There is a complex of drug and antidrug antibody, which binds to an antigen on the red cell • The antibody can be either Ig. M or Ig. G and fixes complement • The antibody often has relatively low avidity; it binds to the complex on the cell membrane, fixes complement, and then dissociates from the cell surface. Leaves the complement on the cell surface alone • The DAT is therefore positive for complement but usually not for immunoglobulins • The complement cascade often proceeds through formation of the membrane attack complex • Hemolysis is usually intravascular, often sudden and severe, and may be associated with acute renal failure • The reaction may occur with low doses of the medication • Medications that can cause this type of reaction include cephalosporin antibiotics, quinine, quinidine, and stibophen
Autoimmune (α-methyldopa) type • The antibody is directed against a red cell antigen, not against the drug itself • The characteristics are similar to those of idiopathic warm-reactive immune hemolytic anemia • It is common for patients on α-methyldopa to develop a positive DAT (~8– 36%), but immune hemolysis is rare (≤ 1%) • The incidence of positive DAT increases with the dose of medication and usually occurs about 3 to 6 months after the medication has been started • The DAT is positive for Ig. G with or without complement and may be positive even in the absence of the drug • A similar reaction can be seen with levodopa and procainamide
Clinical Manifestations & Evaluation • The most common presentation is an insidious onset of fatigue, pallor, and jaundice • Patients with the neoantigen-type reaction are at risk of developing acute fulminant hemolysis with hemoglobinuria and acute renal failure • It is critical to obtain a complete history of drugs and medications in any case of possible immune hemolytic anemia • The presence of an immune reaction is confirmed by the presence of a positive DAT • In some cases, it may be possible to demonstrate the reaction using drug-treated red cells or a combination of the patient’s serum, drug, and reagent red cells • Generally a presumptive diagnosis of drug-related immune hemolytic anemia is made by excluding other causes for immune hemolytic anemia, stopping the drug, and observing to see if the patient improves
NON-IMMUNOLOGIC ACQUIRED HEMOLYTIC ANEMIAS
Mechanical Hemolytic Anemias (I) • A common cause of mechanical hemolysis is a malfunctioning mechanical (or damaged) heart valve • Erythrocytes are crushed by the valve leaflets as they close, resulting in fragmentation and a chronic intravascular hemolysis • Hemoglobin is filtered by glomeruli and phagocytized by renal tubular epithelial cells • The iron is converted to hemosiderin and eventually lost as the tubular epithelial cells are shed into the urine; this may result in iron deficiency • The diagnosis can be made by noting a heart murmur from the malfunctioning valve, schistocytes on blood smear, and a positive urine hemosiderin test • The treatment is iron supplementation and replacement of the malfunctioning valve
Mechanical Hemolytic Anemias (II) • “March hemoglobinuria” can occur during long marches or marathons, resulting from erythrocytes being crushed in the capillaries of the soles of the feet as they pound against the surface • This can be prevented by wearing thicker socks and softer-soled shoes • The microangiopathic hemolytic anemias (sometimes called thrombotic microangiopathies) include thrombotic thrombocytopenic purpura (TTP), hemolytic-uremic syndrome (HUS), preeclampsia/eclampsia, malignant hypertension, and sometimes disseminated intravascular coagulation (DIC) • Fibrin strands form within the capillaries, slicing erythrocytes into fragments as they pass through
Other Causes of Mechanical Hemolysis (I) • Severe burns and othermal injury may result in fragmentation of erythrocytes due to denaturation of cell membrane proteins. The blood smear shows schistocytes, spherocytes, and echinocytes • Acanthocytosis. Acanthocytes are produced by severe disturbances in lipid metabolism, resulting in abnormalities in the phospholipids of the cell membrane. (Hereditary abetalipoproteinemia, Severe liver disease, Severe starvation and anorexia nervosa) • Wilson’s Disease: Acute Copper Poisoning Some patients develop an abrupt onset of hemolysis due to sudden release of copper from the liver. Excess inorganic copper damages RBC membranes, disrupts cellular metabolism, and accelerates the oxidation of hemoglobin, all of which result in decreased cell survival
Other Causes of Mechanical Hemolysis (II) • Oxidative Drugs and Chemicals, may cause hemolysis in people with apparently normal erythrocytes, as well as in patients with G 6 PD and other enzyme deficiencies • Infections. Some infections directly attack the erythrocyte e. g malaria, babesiasis, bartonellosis, trypanosomiasis (African sleeping sickness), Other infections can cause hemolysis without direct infection of the RBC e. g septicemia with Clostridium perfringens (the organism produces a lysolecithinase that damages the RBC membrane). A wide variety of other infections can also be associated with hemolysis including grampositive and gram-negative septicemia, leptospirosis, Borrelia, tuberculosis and toxoplasmosis, among others
Paroxysmal Nocturnal Hemoglobinuria (I) Pathophysiology (I) • Paroxysmal nocturnal hemoglobinuria is an acquired genetic disorder that results in increased susceptibility of RBCs to lysis by the complement system • The condition results from an inability to synthesize some of the glycosyl phosphatidylinositol (GPI) anchor, Among the molecules that use the GPI anchor are the membrane inhibitor of reactive lysis (MIRL; CD 59), decay accelerating factor (DAF; CD 55), and the homologous restriction factor (C 8 binding protein), which are all involved in the RBC defense against complement • Lacking these molecules, erythrocytes are unusually sensitive to lysis by complement and are unable to withstand the low level of complement activation that occurs normally. This results in intravascular hemolysis
Paroxysmal Nocturnal Hemoglobinuria (II) • • Pathophysiology (II) Paroxysmal nocturnal hemoglobinuria results from a mutation in the PIG-A gene on the X chromosome, which encodes for one portion of the GPI anchor. Analysis of G 6 PD isoenzymes and other genetic markers has shown that PNH is a clonal disorder The same defect is found in granulocytes, megakaryocytes, and other blood cells, indicating that the mutation occurs at the level of the hematopoietic stem cell Paroxysmal nocturnal hemoglobinuria frequently arises from, or transforms into, aplastic anemia This has led to speculation that PNH represents escape from immunologic surveillance. Several of the antigens that are missing in PNH are involved in immune recognition, and the absence of these molecules on hematopoietic stem cells would make them less susceptible to recognition by the immune system. Thus, in that circumstance, the PNH clone would have a proliferative advantage over normal cells and would eventually take over the marrow
Paroxysmal Nocturnal Hemoglobinuria (III) • • • Clinical Manifestations (I) Paroxysmal nocturnal hemoglobinuria occurs at all ages from childhood to old age but is most commonly diagnosed in the fourth and fifth decades The course is highly variable, from clinically benign to a chronic disabling disorder The name paroxysmal nocturnal hemoglobinuria derived from patients who experienced episodes of dark urine on awakening from sleep (occurs in only about one-fourth of patients) The majority of patients have an insidious onset of fatigue, weakness, and jaundice Many have periodic exacerbations of hemolysis
Paroxysmal Nocturnal Hemoglobinuria (IV) • • Clinical Manifestations (II) In most cases, there is no obvious cause for the exacerbations, but some attacks may be precipitated by infections, menstruation, transfusions, surgery, ingestion of iron salts, or vaccinations. The attacks are not precipitated by exposure to cold, distinguishing PNH from paroxysmal cold hemoglobinuria Patients may experience abdominal or back pain, nausea, headaches, malaise, and fever associated with exacerbations of hemolysis Unexplained pancytopenia may also be a presenting manifestation of PNH Many patients with myelodysplasia can also be shown to have erythrocytes with increased sensitivity to complement
Paroxysmal Nocturnal Hemoglobinuria (V) Complications (I) • Thromboemboli: accounts for approximately half of the deaths. Thrombi predominantly occur in the venous system, including unusual sites such as the cerebral veins, mesenteric veins, portal vein, and hepatic vein (Budd-Chiari syndrome), as well as in the extremities. The reason for the increased risk of thrombosis in PNH is unknown. • Infections: risk is increased due to leukopenia, leukocyte dysfunction, or corticosteroid therapy. Infections can precipitate exacerbations of hemolysis and account for approximately 10% of deaths in patients with PNH. • Iron deficiency: Chronic intravascular hemolysis with hemoglobinuria results in iron deficiency, which further exacerbates the tendency for anemia.
Paroxysmal Nocturnal Hemoglobinuria (VI) • • Complications (II) Leukopenia, thrombocytopenia, or pancytopenia: Nearly all patients develop leukopenia, thrombocytopenia, or pancytopenia Hemorrhage: Patients with PNH and severe thrombocytopenia are at increased risk for hemorrhage Transformation to acute myelogenous leukemia: A rare but well known complication of PNH Development of aplastic anemia: Up to 30% of patients with PNH have a preceding history of aplastic anemia. In addition, an additional 10% of patients may develop aplastic anemia following the diagnosis of PNH
Paroxysmal Nocturnal Hemoglobinuria (VII) • • • Diagnosis (I) Anemia is the main finding (vary from mild to severe) may be mildly macrocytic but can be microcytic and hypochromic Leukopenia and/or thrombocytopenia are also common Lactic dehydrogenase and bilirubin may be elevated during exacerbations of hemolysis A test for urine hemosiderin will be positive The bone marrow examination generally shows erythroid hyperplasia; bone marrow cellularity is usually increased but can also be normal or decreased
Paroxysmal Nocturnal Hemoglobinuria (VIII) Diagnosis (II) • The traditional diagnostic tests are the acidified serum (Ham’s) test and the sucrose hemolysis test. Both tests depend on activating the complement system and demonstrating increased sensitivity of the cells to complementmediated lysis • Demonstration of a decreased expression MIRL (CD 59) and DAF (CD 55), FLAER (a bacterial channel-forming toxin (proaerolysin) which binds specifically to the GPI anchor) on RBCs or leukocytes by flow cytometry has been shown to be more sensitive than either of these tests
Paroxysmal Nocturnal Hemoglobinuria (IX) • • • When PNH should be suspected Hemoglobinuria due to intravascular hemolysis Hemolytic anemia with a low platelet and/or low neutrophil count Hemolytic anemia and recurrent abdominal pain with or without blood in stool Hepatic vein thrombosis (Budd-Chiari syndrome) Any venous thrombosis anywhere in young adult with low platelet and/or the neutrophil counts Idiopathic pancytopenia (IAA)
Paroxysmal Nocturnal Hemoglobinuria (X) • • • Treatment Standard treatments for PNH include corticosteroids androgens. Both are helpful in some patients and should be tried Patients who respond should be maintained on minimally effective doses to avoid side effects Transfusions may be needed for severe anemia Iron replacement may be helpful in patients who develop iron deficiency; however, iron replacement can occasionally cause acute exacerbations of hemolysis, so a small test dose is recommended Thrombotic episodes are treated with anticoagulants or thrombolytic agents Hematopoietic stem cell replacement (bone marrow transplantation) has been tried in a few younger patients with histocompatible donors, and has been relatively successful
Paroxysmal Nocturnal Hemoglobinuria (XI) Treatment (Eculizumab) • Eculizumab — Eculizumab is a humanized monoclonal antibody that binds to the C 5 component of complement and inhibits terminal complement activation. This agent reduces hemolysis and transfusion requirements. Causes an improvement in the quality of life, including improvement in fatigue and the symptoms of nitric oxide (NO) depletion (eg, esophageal spasm, abdominal pain, erectile dysfunction, renal dysfunction, and pulmonary hypertension). • Eculizumab (600 mg) was given by infusion every week for four weeks, followed one week later by 900 mg given every two weeks through week 26.
Paroxysmal Nocturnal Hemoglobinuria (XI) Prognosis The median survival in PNH is approximately 10 to 15 years, and some patients live for 25 years or longer. Rare cases of spontaneous recovery have been reported.